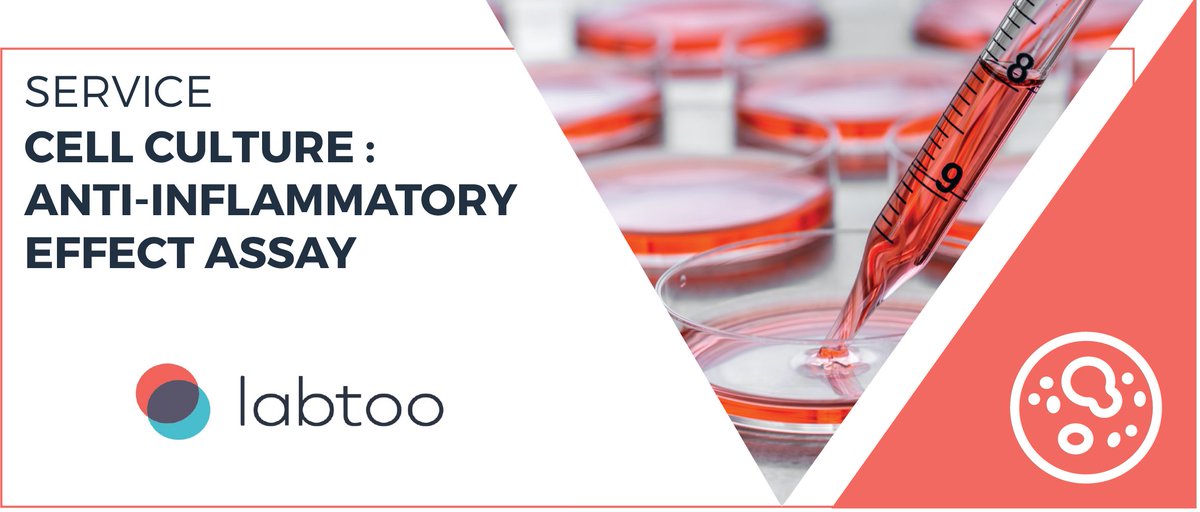
📌 Focus on one of our expertise :

Two types of anti-inflammatory effect assays are possible: a cell test of the activity of the NFkB promoter, and a cell test measuring inflammation markers (cytokines).

Order your  tests on Labtoo ⬇️
ow.ly/gk5k50xBSVR

<a href="/SelvitaKrakow/">Selvita</a>

labtoo
@labtoo
The European Marketplace for Scientific Research
🧪Order scientific experiments
👩🔬Market your expertise
#research #collaboration #expertise #startup #biotech
ID: 798541807273541633
https://www.labtoo.com 15-11-2016 15:02:57
446 Tweet
656 Followers
664 Following



🙌 In this Labiotech.eu article, discover ten #eco-friendly applications of #biotech! ow.ly/sHfM50xg20F From enzyme #recycling to biological fertilizers or #ecological dyes, the fields of application of biotech are vast and are only expanding ✨ @Carbios @_PILIbio

🙌Pierre's journey at the iGEM Headquarters synthetic biology contest! ow.ly/O5Z550xiera In this article of our #blog, Pierre explains why he joined the IGEM 2021 Sorbonne Université Paris team, how their project was born and what the results of the competition were ! ✨ Sorbonne Université #environment


📌 Focus on one of our expertise: Monoclonal antibodies are widely used in medicine and biology, both for diagnosis and therapy. Find this expertise on Labtoo ! 👇 ow.ly/GE5z50xkHor Fusion Antibodies


📅 Save the date! The #BioFIT event will take place in two weeks in Marseille ✨ BioFIT is the leading event in Europe for technology transfer in the field of Life Sciences 👇 ow.ly/5vSB50xlN0L @Eurasante @ClubsterNSL @BioValleyFrance Eurobiomed #biotech #science